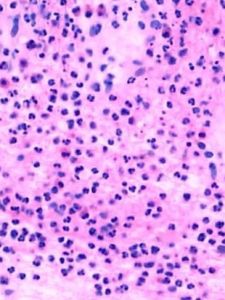
皰疹樣皮炎

發病原因
皰疹樣皮炎關於皰疹樣皮炎的發病原因,目前尚未有定論,大多數學者認為該病與患者免疫異常及小腸病變有關。
(1)免疫異常在患者的皮損和正常皮膚真皮層有免疫物質沉積,在螢光顯微鏡下可見到它們呈顆粒狀。另外,大約70%的患者血中可以找到特殊的抗體及免疫複合物。這些均提示皰疹樣皮炎與患者自身免疫異常有關。
(2)腸病變約70%~90%的患者有小腸病變,臨床表現為大便溏瀉,做大便常規檢查,會發現很多脂肪小顆粒,這說明患者腸功能異常。做組織病理檢查,會看到小腸黏膜的絨毛萎縮變平,黏膜下有淋巴細胞浸潤,如果患者吃了含麵筋(學名谷膠,又名麥膠)的食物,如小麥、大麥、燕麥、黑麥,就會使患者皮膚症狀及腸功能異常加重,假如給予不含麵筋的食物,皮損和腸功能異常就會改善。這說明皰疹樣皮炎患者存在對谷膠的敏感性。
臨床表現
皰疹樣皮炎[主要臨床表現]
1. 損害呈對呈分布於肩胛、臂、骶及四肢伸側,皮損對稱分布。
2. 皮疹呈多形性,成群或排列呈環形,葡行性或地圖形。
3. 劇烈瘙癢,為早期症狀,夜間尤甚。
4. 水皰緊張壁厚不易破,尼氏征陰性。
5. 碘化鉀可加重病情。
臨床表現
皰疹樣皮炎1.初起為點狀紅斑或小丘疹,迅速變為粟粒、豌豆或更大的水皰,約1—2日後,水皰變為膿皰。
2。由金黃色葡萄球菌所致者,亦稱大皰性膿皰瘡。膿皰較大,壁薄而鬆弛,皰液渾濁,膿汁沉積於皰底部,成半月形的積膿現象,破後露出糜爛面,乾燥後形成黃色膿痂。
3.由溶血性鏈球菌或與金黃色葡萄球菌混合感染者,亦稱膿痂性膿皰瘡。膿皰皰壁較厚,紅暈顯著,膿皰破後其滲液乾燥結成蜜黃色厚痂。
4.多發於顏面、四肢等暴露部位。自覺瘙癢,常因搔抓而不斷接種新疹。
5,主要發於2-7歲兒童,多見於夏秋季節、接觸傳染,可兒童中流行。
[診斷]
1.根據臨床表現即可診斷。
2.需與水痘相鑑別,後者多見於冬秋季節。發疹時常伴有發熱等全身症狀,皮疹為向心性分布,以綠豆大到黃豆大的水皰為主,同時可見到丘疹、結痂等各期皮疹,口腔黏膜亦可受累。
[治療]
1.西醫藥治療
(1)全身治療:對於皮損廣泛,伴有發熱或淋巴結炎者,可給予磺胺藥或抗生素製劑。
(2)局部治療:以殺菌、消炎、止癢、乾燥為原則。皰壁未破者可外搽1%樟腦、10%硫黃爐甘石洗劑,每日數次。皰壁已破形成糜爛面或結痂者,可先以O.1%利凡諾溶液濕敷,敷後外用O.5%新黴素軟膏或百多邦軟膏、環丙沙星軟膏等,亦可用2%龍膽紫溶液。
皰疹樣皮炎(1)內治法:症見膿皰周圍有炎性紅暈,破後糜爛結膿痂,可伴發熱、口渴、納呆、便乾尿黃,舌紅、苔薄黃,脈滑數。症屬肺胃濕熱,外感毒邪。
治法:清熱解毒利濕。
方藥:蒲公英10克、地丁10克、野菊花10克、金銀花10克、黃芩10克、生地10克、澤瀉10克、滑石30克(包煎)、生甘草6克。
(2)外治法
①如意金黃散以涼茶調後外搽患處。
②馬齒莧30克、苦參30克,水煎濕敷患處。
③顛倒散(大黃、硫黃各等份)洗劑外搽。
預防與調養]
1.普及衛生教育,尤其對託兒,所、幼稚園的保育員、教養員,以防本病流行
2.注意清潔衛生,經常修剪指甲,勤洗手、勤洗澡、勤換衣服。
3.保護皮膚完整,即使皮膚有極細小的破損,也應及時塗些紅藥水或龍膽紫,以防感染。如有濕疹、蟲咬皮炎等瘙癢性皮膚病,應早期積極治療,切忌搔抓。在暑天,防痱治痱對預防本病有重要意義。
4.產房嬰兒室、託兒所或幼稚園如有發病應及時隔離治療,嚴密消毒
檢查
1.實驗室檢查(1)血液中嗜酸性粒細胞升高,分類計數最高可達0.40。
(2)25%~50%碘化鉀軟膏做斑貼試驗,多數患者24小時內局部出現紅斑、水皰。
2.免疫學檢查
(1)直接免疫螢光檢查皮損周圍3mm內外觀正常皮膚或淡紅斑處,90%患者真皮乳頭有顆粒狀IgA和C3沉積。水皰處由於炎症的破壞常呈陰性結果。
(2)血清學研究少數患者血清IgA升高,IgM減低,在谷膠敏感性腸病患者中90%常有IgA抗肌內膜抗體。36%患者有抗網狀纖維抗體IgG和2/3患者有抗麥膠蛋白抗體。
(3)免疫遺傳學白細胞表面組織相容性抗原(HLA)測定,發現HLA-B8、HLA-DR3、HLA-DQw2陽性率分別為90%、95%和100%,比正常人30%、23%和40%明顯增高。
3.組織病理學檢查
早期真皮乳頭頂部毛細血管周圍有較多中性及嗜酸性粒細胞浸潤,形成以中性粒細胞為主的小膿腫,使該處膠原纖維發生溶解,使乳頭頂部與表皮分離,形成多房性水皰。36小時後,由於滲出加重,融合成單房性表皮下大皰。真皮內血管周圍有多數嗜酸性粒細胞及中性粒細胞浸潤,偶見血管炎改變。
診斷
根據多形性皮疹,以水皰為主,排列呈環形,好發於肩胛、臀部和四肢伸側,對稱分布,劇烈瘙癢,尼氏征陰性,有時伴有吸收不良表現,組織病理為表皮下水皰,真皮乳頭有中性粒細胞小膿腫,IgA呈顆粒狀沉積,碸類藥物有較好的治療效果,可診斷。鑑別診斷
需與皰疹型天皰瘡、大皰性類天皰瘡、多形紅斑和大皰性表皮鬆解症相鑑別。治療
1.一般治療避免吃含碘劑、溴劑的藥物(如華素片)和食物(如紫菜、海帶),宜無谷膠(麵筋)飲食。
2.全身治療
(1)氨苯碸每日2次或3次口服,可在1~3天之內緩解瘙癢等症狀。若症狀無改善,遵醫囑適當增加劑量。
(2)磺胺吡啶無氨苯碸效果好。
接受氨苯碸和磺胺吡啶治療的皰疹樣皮炎病人,在治療前和治療後的前4周,每周要檢查血常規,以後8周,每2~3周檢查1次,繼之每12~16周檢查1次,因為隨時可能發生粒細胞缺乏症。溶血性貧血和高鐵血紅蛋白血症是最常見的副反應。這些副反應在遺傳性葡萄糖-6-磷酸脫氫酶(G6PD)缺乏的患者非常嚴重。中樞神經系統或肝臟毒性反應罕見。如果使用氨苯碸治療引起溶血,明顯心肺功能障礙或周圍神經病變,應考慮改用磺胺吡啶。磺胺吡啶一般不會引起溶血。
某些皰疹樣皮炎患者通過嚴格而長期的(如6~12個月)無谷膠飲食,不用或少用藥物治療也可控制病情。
3.局部治療
以止癢、消炎和預防繼發感染為主。
預防
部分病人對谷膠過敏,限制谷膠飲食後,病情可自然好轉,同時亦應避免含碘、溴、氯的食物、藥物。治療原則
皰疹樣皮炎[護理重點]
1. 按皮膚科一般常規護理。
2. 避免吃含碘劑、溴劑的藥物和食物,如海帶、紫菜等。忌用含有谷膠,如麥類製作的食物。
3. 定時剪指甲,防止感染,注意皮膚清潔衛生,保持床單的平整乾燥。
皰疹性皮炎是一種少見的慢性良性復發性皮膚病,皮疹呈多形性對稱分布,劇烈瘙癢,病因不明,可能是自身免疫性疾病。
[診斷要點]
(1)自覺劇烈瘙癢,尤以夜間為重。
(2)皮損特點皮損呈多形性,有紅斑、丘疹、風團及大小不等之水皰,以成群分布之漿液性水皰為特徵。皰壁厚而緊張,不易破裂,無棘層細胞松解現象。
皰疹樣皮炎(4)多發於四肢伸側。
(5)慢性經過,反覆發作加重與緩解。
[飲食療法]
方1芹菜250克,每日當菜吃,炒或涼拌均可,連續多吃,能迅速乾燥脫皮,不癢而愈。
方2蓮花3~4.5克,加水煎汁,代茶飲。也可搗爛敷患處
方3馬齒莧、赤小豆、絲瓜皮、苧麻根、巴蕉根、菊花根各等量,焙乾研細末,每用適量,以米泔水調勻塗之,每日3次。
方4龍葵莖葉100克,紫花地丁30克,加水煎洗患處。
方5淮山藥30克,生扁豆15克,生芡實15克,生苡米15克,茯苓10克,澤瀉10克,車前草15克,川萆10克,白鮮皮15克,黃柏10克,丹皮10克,地膚子10克,加水適量煎服。每日1劑。
皰疹樣皮炎(1)忌致敏食物。
(2)忌辛辣刺激食物。
(3)忌發濕,動血、動氣食物。
(4)良姜急性單純皰疹不宜多食,良姜多作肉食中的調料,良姜性溫熱,肉食品也可生熱,急性單純皰疹多食後會加重病情。
疾病大全(一)
| 疾病是人體健康的殺手,了解疾病、預防疾病、治療疾病一直是廣大醫務工作者為之奮鬥的目標。然而預防疾病也是我們每個人必須做到的。在這裡讓我們通過對一些疾病的了解來加強人類對疾病的防範意識,杜絕疾病的發生,減少人間的慘劇! |